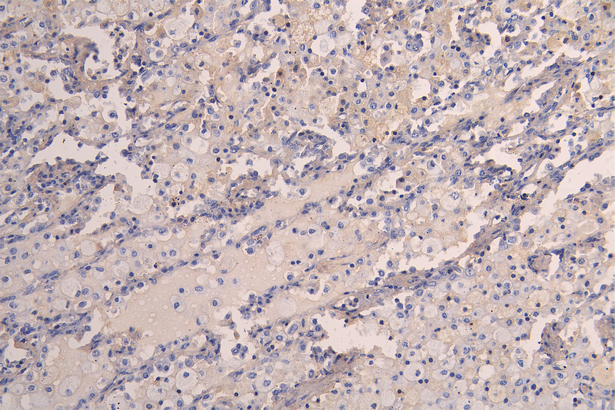

KDR Recombinant Monoclonal Antibody
-
中文名稱:KDR重組抗體
-
貨號:CSB-RA012145MA1HU
-
規(guī)格:¥1320
-
圖片:
-
IHC image of CSB-RA012145MA1HU diluted at 1:200 and staining in paraffin-embedded human lung tissue performed on a Leica BondTM system. After dewaxing and hydration, antigen retrieval was mediated by high pressure in a citrate buffer (pH 6.0). Section was blocked with 10% normal goat serum 30min at RT. Then primary antibody (1% BSA) was incubated at 4°C overnight. The primary is detected by a Goat anti-human polymer IgG labeled by HRP and visualized using 0.05% DAB.
-
-
其他:
產(chǎn)品詳情
-
產(chǎn)品描述:CSB-RA012145MA1HU KDR重組單克隆抗體是經(jīng)過嚴格驗證的科研用試劑,靶向血管內(nèi)皮生長因子受體2(VEGFR2/KDR),該受體在血管生成、內(nèi)皮細胞增殖及腫瘤血管形成等病理生理過程中起核心調(diào)控作用。本產(chǎn)品經(jīng)ELISA和免疫組化(IHC)雙平臺驗證,在IHC實驗中展現(xiàn)優(yōu)異的組織特異性,推薦使用稀釋度為1:50-1:200,可在多種組織樣本中實現(xiàn)清晰的膜定位信號與低背景染色,且不同批次間穩(wěn)定性一致。其高親和力特性支持對石蠟包埋組織切片中KDR蛋白表達的精準檢測,適用于腫瘤血管生成機制、心血管疾病模型及發(fā)育生物學等領(lǐng)域的研究,尤其為探索腫瘤微環(huán)境中血管內(nèi)皮細胞活化、藥物靶向治療響應(yīng)等課題提供可靠工具。該抗體不適用于活體診斷或治療,嚴格限于體外科研分析。
-
Uniprot No.:
-
基因名:
-
別名:CD309 antibody; CD309 antigen antibody; EC 2.7.10.1 antibody; Fetal liver kinase 1 antibody; FLK-1 antibody; FLK1 antibody; FLK1, mouse, homolog of antibody; Kdr antibody; Kinase insert domain receptor (a type III receptor tyrosine kinase) antibody; Kinase insert domain receptor antibody; KRD1 antibody; Ly73 antibody; Protein tyrosine kinase receptor FLK1 antibody; Protein-tyrosine kinase receptor flk-1 antibody; soluble VEGFR2 antibody; Tyrosine kinase growth factor receptor antibody; Vascular endothelial growth factor receptor 2 antibody; VEGFR 2 antibody; VEGFR antibody; VEGFR-2 antibody; VEGFR2 antibody; VGFR2_HUMAN antibody
-
反應(yīng)種屬:Human
-
免疫原:Recombinant Human KDR protein
-
免疫原種屬:Homo sapiens (Human)
-
標記方式:Non-conjugated
-
克隆類型:Monoclonal
-
抗體亞型:hIgG1
-
純化方式:Affinity-chromatography
-
克隆號:11F8
-
濃度:It differs from different batches. Please contact us to confirm it.
-
保存緩沖液:Preservative: 0.03% Proclin 300
Constituents: 50% Glycerol, 0.01M PBS, PH 7.4 -
產(chǎn)品提供形式:Liquid
-
應(yīng)用范圍:ELISA, IHC
-
推薦稀釋比:
Application Recommended Dilution IHC 1:50-1:200 -
Protocols:
-
儲存條件:Upon receipt, store at -20°C or -80°C. Avoid repeated freeze.
-
貨期:Basically, we can dispatch the products out in 1-3 working days after receiving your orders. Delivery time maybe differs from different purchasing way or location, please kindly consult your local distributors for specific delivery time.
-
用途:For Research Use Only. Not for use in diagnostic or therapeutic procedures.
相關(guān)產(chǎn)品
靶點詳情
-
功能:Tyrosine-protein kinase that acts as a cell-surface receptor for VEGFA, VEGFC and VEGFD. Plays an essential role in the regulation of angiogenesis, vascular development, vascular permeability, and embryonic hematopoiesis. Promotes proliferation, survival, migration and differentiation of endothelial cells. Promotes reorganization of the actin cytoskeleton. Isoforms lacking a transmembrane domain, such as isoform 2 and isoform 3, may function as decoy receptors for VEGFA, VEGFC and/or VEGFD. Isoform 2 plays an important role as negative regulator of VEGFA- and VEGFC-mediated lymphangiogenesis by limiting the amount of free VEGFA and/or VEGFC and preventing their binding to FLT4. Modulates FLT1 and FLT4 signaling by forming heterodimers. Binding of vascular growth factors to isoform 1 leads to the activation of several signaling cascades. Activation of PLCG1 leads to the production of the cellular signaling molecules diacylglycerol and inositol 1,4,5-trisphosphate and the activation of protein kinase C. Mediates activation of MAPK1/ERK2, MAPK3/ERK1 and the MAP kinase signaling pathway, as well as of the AKT1 signaling pathway. Mediates phosphorylation of PIK3R1, the regulatory subunit of phosphatidylinositol 3-kinase, reorganization of the actin cytoskeleton and activation of PTK2/FAK1. Required for VEGFA-mediated induction of NOS2 and NOS3, leading to the production of the signaling molecule nitric oxide (NO) by endothelial cells. Phosphorylates PLCG1. Promotes phosphorylation of FYN, NCK1, NOS3, PIK3R1, PTK2/FAK1 and SRC.
-
基因功能參考文獻:
- The findings indicate that miR-203a inhibits hepatocellular carcinoma cell invasion, metastasis, and angiogenesis by negatively targeting HOXD3 and suppressing cell signaling through the VEGFR pathway. PMID: 29402992
- these results indicate that sFlt-1 up-regulation by VEGF may be mediated by the VEGF/Flt-1 and/or VEGF/KDR signaling pathways. PMID: 29497919
- miR424 may target VEGFR2 and inhibit Hemangioma derived endothelial cell growth. PMID: 30132564
- VEGFR2 is regulated by deSUMOylation during pathological angiogenesis. PMID: 30120232
- This study shows that decreasing the ratio of glutathione to oxidized glutathione with diamide leads to enhanced protein S-glutathionylation, increased reactive oxygen species (ROS) production, and enhanced VEGFR2 activation. PMID: 30096614
- Study confirmed prognostic effect of EGFR and VEGFR2 for recurrent disease and survival rates in patients with epithelial ovarian cancer. PMID: 30066848
- none of the investigated VEGFR-2 gene polymorphisms was found to be an independent prognostic marker for infantile hemangioma. PMID: 29984822
- These results suggest functional interactions among ATX, VEGFR-2, and VEGFR-3 in the modulation of hemovascular and lymphovascular cell activation during vascular development. PMID: 30456868
- miR-195 suppresses cell proliferation of ovarian cancer cells through regulation of VEGFR2 and AKT signaling pathways. PMID: 29845300
- Thioredoxin-interacting protein (TXNIP) is highly induced in retinal vascular endothelial cells under diabetic conditions. Data (including data from studies using knockout mice) suggest that TXNIP in retinal vascular endothelial cells plays role in diabetic retinal angiogenesis via VEGF/VEGFR2 and Akt/mTOR signaling. PMID: 29203232
- Inhibition of FPR1 and/or NADPH oxidase functions prevents VEGFR2 transactivation and the triggering of the downstream signalling cascades. PMID: 29743977
- VEGFA activates VEGFR1 homodimers and AKT, leading to a cytoprotective response, whilst abluminal VEGFA induces vascular leakage via VEGFR2 homodimers and p38 PMID: 29734754
- association of rs519664[T] in TTC39B on 9p22 with endometriosis, is reported. PMID: 27453397
- VEGF, VEGFR2 and GSTM1 polymorphisms in outcome of multiple myeloma patients treated with thalidomide-based regimens PMID: 28665417
- In the in vitro tests, JFD-WS effectively inhibited HUVEC proliferation, migration, tube formation and VEGFR2 phosphorylation. Additionally, JFD-WS inhibited the formation of blood vessels in chick chorioallantoic membrane. While inhibiting the xenograft tumor growth in experimental mice, JFD-WS decreased the plasma MUC1 levels PMID: 29436685
- The effects of Platelet-rich plasma on vascular endothelial growth factor receptor-2 (VEGFR2) and CD34 expression were evaluated using real-time PCR, flow cytometry, western blot, immunocytochemistry and pathological study, as were carried out in both human umbilical endothelial cell culture and rat skin PMID: 28948378
- metformin's dual effect in hyperglycemia-chemical hypoxia is mediated by direct effect on VEGFR1/R2 leading to activation of cell migration through MMP16 and ROCK1 upregulation, and inhibition of apoptosis by increase in phospho-ERK1/2 and FABP4, components of VEGF signaling cascades PMID: 29351188
- Single nucleotide polymorphism of VEGFR2 is associated with relapse in gastroenteropancreatic neuroendocrine neoplasms. PMID: 29787601
- Our data showed that ampelopsin inhibited angiogenesis with no cytotoxicity by suppressing both VEGFR2 signaling and HIF-1alpha expression. These results suggest that Hovenia dulcis Thunb. and its active compound ampelopsin exhibit potent antiangiogenic activities and therefore could be valuable for the prevention and treatment of angiogenesis-related diseases including cancer. PMID: 29039561
- Authors demonstrated that when VEGFR2 was inhibited, NRP-1 appeared to regulate RAD51 expression through the VEGFR2-independent ABL-1 pathway, consequently regulating radiation sensitivity. In addition, the combined inhibition of VEGFR2 and NRP-1 appears to sensitize cancer cells to radiation. PMID: 29777301
- We found that depletion of FGD5 in microvascular cells inhibited their migration towards a stable VEGFA gradient. Furthermore, depletion of FGD5 resulted in accelerated VEGFR2 degradation, which was reverted by lactacystin-mediated proteasomal inhibition. Our results thus suggest a mechanism whereby FGD5 sustains VEGFA signaling and endothelial cell chemotaxis via inhibition of proteasome-dependent VEGFR2 degradation. PMID: 28927665
- ATG5 and phospho-KDR expression was strongly associated with the density of vasculogenic mimicry in tumors and poor clinical outcome. PMID: 28812437
- Increased expression of VEGFR2 correlated with differentiation. PMID: 28854900
- DDA exhibits anti-angiogenic properties through suppressing VEGF-A and VEGFR2 signaling PMID: 27517319
- RCAN1.4 plays a novel role in regulating endothelial cell migration by establishing endothelial cell polarity in response to VEGF. PMID: 28271280
- Anlotinib occupied the ATP-binding pocket of VEGFR2 tyrosine kinase. PMID: 29446853
- the difference between the pro- (VEGF165a) and antiangiogenic (VEGF165b) VEGF isoforms and its soluble receptors for severity of diabetic retinopathy, is reported. PMID: 28680264
- anlotinib inhibits the activation of VEGFR2, PDGFRbeta and FGFR1 as well their common downstream ERK signaling PMID: 29454091
- upregulation of sVEGFR-1 with concomitant decline of PECAM-1 and sVEGFR-2 levels in preeclampsia compared to normotensive pregnancies, Irrespective of the HIV status PMID: 28609170
- by inhibiting the phosphorylation of VEGFR2, the P18 peptide ( functional fragment of pigment epithelial-derived factor (PEDF)modulates signalling transduction between VEGF/VEGFR2 and suppresses activation of the PI3K/Akt cascades, leading to an increase in mitochondrial-mediated apoptosis and anti-angiogenic activity. PMID: 28627623
- VEGF increases arginine transport via modulation of CAT-1 in endothelial cells. This effect is exclusively dependent on KDR rather than Flt-1. PMID: 28478454
- this study shows that glioma stem cells-derived exosomes promote the angiogenic ability of endothelial cells through miR-21/VEGF/VEGFR2 signal pathway PMID: 28410224
- MEG3 regulated by HIF-1alpha is required to maintain VEGFR2 expression in endothelial cells and plays a vital role for VEGFA-mediated endothelial angiogenesis. PMID: 29391273
- Overexpression of peroxiredoxin 2 and VEGFR2 in pterygium might be involved in the pathogenesis or recurrence of pterygium. The increase of VEGFR2 might be related to the increase of peroxiredoxin 2 in response to excessive reactive oxygen species from ultraviolet exposure. PMID: 28489720
- KDR -604T > C (rs2071559) polymorphism showed no significant association with multiple sclerosis. PMID: 28401369
- The up-regulation of NHERF1 induced by the exposure to hypoxia in colon cancer cells depends on the activation of VEGFR2 signaling. PMID: 27999191
- JAM-C plays an important role in maintaining VEGR2 expression to promote retinal pigment epithelial cell survival under oxidative stress. PMID: 28203682
- Data suggest that diabetic nephropathy is associated with diminished VEGF-A levels in the kidney; VEGF-A/VEGFR-2 signaling is influenced by the local milieu. [REVIEW] PMID: 27836681
- this paper shows that cell-permeable iron inhibits vascular endothelial growth factor receptor-2 signaling and tumor angiogenesis PMID: 27589831
- Eriocalyxin B inhibited VEGF-induced angiogenesis in HUVECs by suppressing VEGFR-2 signaling. PMID: 27756875
- we found that the KDR fragment with domain 4 induced phosphorylation of VEGFR-2, as well as phosphorylation of downstream receptor kinases in HUVECs and VEGFR-2-positive breast cancer cells. PMID: 28303365
- gremlin protects skin cells from UV damages via activating VEGFR2-Nrf2 signaling PMID: 27713170
- Specificity protein 1 (Sp1) orchestrates the transcription of both VEGF and VEGFR2; hence, Sp1 could act as a therapeutic target. Here, we demonstrate that CF3DODA-Me induced apoptosis, degraded Sp1, inhibited the expression of multiple drivers of the blebbishield emergency program such as VEGFR2, p70S6K, and N-Myc through activation of caspase-3, inhibited reactive oxygen species; and inhibited K-Ras activation to abolis PMID: 28283889
- Icrucumab and ramucirumab are recombinant human IgG1 monoclonal antibodies that bind vascular endothelial growth factor (VEGF) receptors 1 and 2 (VEGFR-1 and -2), respectively. VEGFR-1 activation on endothelial and tumor cell surfaces increases tumor vascularization and growth and supports tumor growth via multiple mechanisms, including contributions to angiogenesis and direct promotion of cancer cell proliferation. PMID: 28220020
- REVIEW. the interplay among the ETS transcription factor ETV2, vascular endothelial growth factor, and its receptor VEGFR2/FLK1 is essential for hematopoietic and vascular development. Emerging studies also support the role of these three factors and possible interplay in hematopoietic and vascular regeneration. PMID: 28026128
- DOT1L cooperates with transcription factor ETS-1 to stimulate the expression of VEGFR2, thereby activating ERK1/2 and AKT signaling pathways and promoting angiogenesis. PMID: 27626484
- This study provides new insights into the mechanism of VEGFR2 dimerization and activation. PMID: 28847506
- Cases with high MDSC infiltration, which was inversely correlated with intratumoral CD8(+) T-cell infiltration, exhibited shorter overall survival. In a mouse model, intratumoral MDSCs expressed both VEGFR1 and VEGFR2. VEGF expression in ovarian cancer induced MDSCs, inhibited local immunity, and contributed to poor prognosis PMID: 27401249
- our results illustrated that CDK5-mediated KDR phosphorylation controls prolactin pituitary adenoma progression and KDR pSer-229 serves as a potential prognostic biomarker for both noninvasive and invasive pituitary adenomas. PMID: 27438154
- Data indicate that simultaneous targeting of molecules that control distinct phases of angiogenesis, such as ALK1 and VEGFR, is a valid strategy for treatment of metastatic renal cell carcinoma (mRCC). PMID: 27248821
顯示更多
收起更多
-
相關(guān)疾病:Hemangioma, capillary infantile (HCI)
-
亞細胞定位:Cell junction. Endoplasmic reticulum. Cell membrane.; [Isoform 1]: Cell membrane; Single-pass type I membrane protein. Cytoplasm. Nucleus. Cytoplasmic vesicle. Early endosome. Note=Detected on caveolae-enriched lipid rafts at the cell surface. Is recycled from the plasma membrane to endosomes and back again. Phosphorylation triggered by VEGFA binding promotes internalization and subsequent degradation. VEGFA binding triggers internalization and translocation to the nucleus.; [Isoform 2]: Secreted.; [Isoform 3]: Secreted.
-
蛋白家族:Protein kinase superfamily, Tyr protein kinase family, CSF-1/PDGF receptor subfamily
-
組織特異性:Detected in cornea (at protein level). Widely expressed.
-
數(shù)據(jù)庫鏈接:
Most popular with customers
-
-
YWHAB Recombinant Monoclonal Antibody
Applications: ELISA, WB, IHC, IF, FC
Species Reactivity: Human, Mouse, Rat
-
Phospho-YAP1 (S127) Recombinant Monoclonal Antibody
Applications: ELISA, WB, IHC
Species Reactivity: Human
-
-
-
-
-